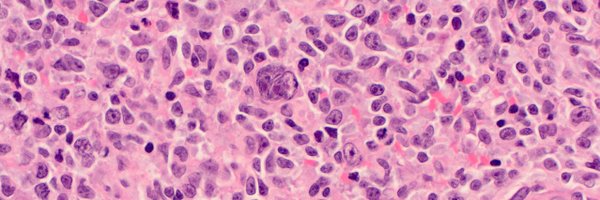
TheLymphomaniac Profile Banner

Matthew Pugh
@TheLymphomaniac
Followers
519
Following
143
Media
5
Statuses
64
FRCPath MRC CRTF, UK, Lymphoma pathology enthusiast. #hemepath #LivingTheHeme #pathology
Wales, United Kingdom
Joined November 2017
Check out our new spatial profiling paper on COVID-19 placentitis showing how the SARS-CoV-2 virus drives the devestating complications of the disease #spatialprofiling #mulitpleximmunohistochemistry @lunaphore @nanostringtech
Delighted to present our new preprint on spatial multi-omic profiling of COVID-19 placentitis, a rare complication of maternal SARS-CoV-2 infection, resulting in poor fetal outcome https://t.co/VU3pbbyLke (1/12) @lunaphore @nanostringtech @BTA_Birmingham @TheLymphomaniac
0
0
6
Get registered for the Pathsoc Winter meeting. A fantastic line with talks on spatial profiling, disease immunology and the digital cancer twin.
Remember, early bird registration for the joint PathSoc @RoySocMed winter meeting on 21st and 22nd of January 2025 has opened! 🔬 Early bird rates until 19th of November 2024. Scan the QR code to register or go to https://t.co/uvSgWhBTl3
0
1
1
Delighted to present our new preprint on spatial multi-omic profiling of COVID-19 placentitis, a rare complication of maternal SARS-CoV-2 infection, resulting in poor fetal outcome https://t.co/VU3pbbyLke (1/12) @lunaphore @nanostringtech @BTA_Birmingham @TheLymphomaniac
4
10
38
It’s official! Since its implementation, #digitalpathology has resulted in yearly efficiency gains of 20%. Our pathologists are happier and better off as a result. This can only be good news for our patients! @janeirosf
12
94
167
What an absolute joke @MotorpointDiff. 1 hour10 mins waiting for the bar and counting
0
0
0
The @ACP_Pathologist @RCPath Wales Pathology Education symposium at @lshubwales is on 6th June and it’s free!! #RCPathWales Register here:
rcpath.org
1
8
7
I created an algorithm for classifying AML according to the new 2017 WHO Classification. Useful for determining which categories take precedence. #hemepath
18
201
336
Special #hemepath guest on my YouTube channel: Dr. Jeanette Ramos teaches me & @ehfultonmd basic #histology & #IHCpath of non-neoplastic lymph nodes. https://t.co/Vg9C7O7Sl0 If you like this, let me know. Should I invite other special guests in future? #pathology #pathologists
12
76
153
Registration is now open for the @RCPath & @ACP_Pathologist Wales Pathology Education Symposium, 6th June @lshubwales It's free! #RCPathWales #meded
https://t.co/oH6de0f8zf
rcpath.org
1
9
15
Do you find thymic pathology super complicated? Here's a super simplified place to start: https://t.co/MvSKf1X5Lq
@deepualexmd @lara_pijuan @SansanoValero @steland011 @tlabiano @edusqo @GeronimoJrLapac
17
80
121
The mutational landscape of PTFL, defined as a 'benign' proliferation... not needing therapy beyond excusing... different from IRF4 mutated DLBCL... architectural distortion is the only way PTFL can be differentiated from reactive FH with clonal follicles. #USCAP2018
2
17
21
Intravenous leiomyoma(tosis). This tumor were extending from right iliac vein through thoracic inferior vena cava. #pathology
4
26
49
Langerhans cells: check out these twisted sistas from a post by @mreyesm Thank you @pembeoltulu for teaching me this cool trick! #pathology
5
93
124
‘Intelligence is the ability to adapt to change’ - Stephen Hawking. An important quote in the current pathology climate and just one of his brilliant insights - RIP 💙
0
5
6
Women's History month is the perfect time to shine spotlight on women in science who are helping to lead these advances. Share a woman trailblazer who inspires you to #FightBloodCancer.
multivu.com
According to a new survey by The Leukemia & Lymphoma Society, most Americans agree women are critical to scientific discovery
0
16
34